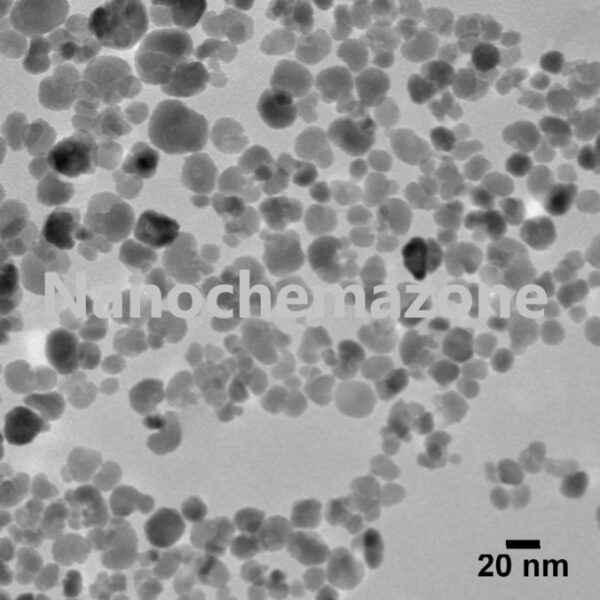

Lanthanum Aluminate (LaAlO₃) Powder Micron and Nano Size
$0.00
Lanthanum Aluminate (LaAlO₃) Micron Powder, High Purity: 99.9%, Size: 10 µm
Lanthanum Aluminate (LaAlO₃) Micron Powder
Purity: 99.9 %, Size: 10 µm
Technical Properties:
| Product Number | NCZ-RE-133-20 |
| PURITY | 99.9 % |
| MORPHOLOGY | Spherical |
| COLOR | Grey |
| SIZE | 10 µm (customize) |
| SPECIFIC SURFACE AREA (m2/g) | 25.0-55.0 |
| MOL. WEIGHT | 213.89 g/mol |
| DENSITY | 6.52 g/cm3 |
| CAS | 12003-65-5 |
Note: We manufacture and supply different particle sizes (Nano size range, Micron, Submicron, and different Mesh size) products of Alloy powders (Multi-Element, Multi-Element Oxide and Mixture of Rare Earth Elements) according to client’s requirements. Kindly ask for the customization in size and Element ratio composition.
Category: Rare Earth Compound Powder
Description
Note: For pricing & ordering information, please contact us at [email protected]
Please contact us for quotes on Larger Quantities & Customization. E-mail: [email protected]
Customization:
If you are planning to order large quantities for your industrial and academic needs, please note that customization of parameters (such as size, length, purity, functionalities, etc.) are available upon request.
Reviews (0)
Only logged in customers who have purchased this product may leave a review.
Shipping & Delivery
Related products
Lanthanum Hexaboride (LaB6) Micron Powder
$0.00
Lanthanum Hexaboride (LaB6) Micron Powder, High Purity: 99.9%, Size: 1-20 µm
Lanthanum Hexaboride (LaB6) Micron Powder
Purity: 99.9 %, Size: 1-20 µm
Technical Properties:
| Product Number | NCZ-RE-130A-19 |
| PURITY | 99.9% |
| AVERAGE PARTICLE SIZE | 1-20 µm (customizable) |
| DENSITY (g/cm3) | 2.7 |
| MELTING POINT | 2210 oC |
Note: We can manufacture and supply different particle sizes (Nano size range, Micron, Submicron, and different Mesh size) products of Alloy powders (Multi-Element, Multi-Element Oxide and Mixture of Rare Earth Elements) according to client’s requirements. Kindly ask for the customization in size and Element ratio composition.
Lanthanum Trifluoride (LaF3) Nanopowder/Nanoparticles
$0.00
Lanthanum Trifluoride Nanopowder
| Product Number | NCZ-RE-131-19 |
| PURITY | 99.9% |
| AVERAGE PARTICLE SIZE | 50 nm |
| Mol. Wt. | 195.9 g/mol |
| Density | 5.9 g/cm³ |
| CAS | 13709-38-1 |
| Color | White |
| Melting Point | 1493 °C (2719 °F) |
Lanthanum Trifluoride Description
Lanthanum Trifluoride Powder
We can manufacture and supply different particle sizes (Nano size range, Micron, Submicron, and different Mesh size) products of Alloy powders and Lanthanum Trifluoride Powder
Multi-Element, Multi-Element Oxide and Mixture of Rare Earth Elements) according to client’s requirements. Kindly ask for the customization in size and Element ratio composition.
Lanthanum Trifluoride Related Information
Storage Conditions: Airtight sealed, avoid light and keep dry at room temperature. Please contact us for customization and price inquiry Email: [email protected] Note: We supply different size ranges of Nano and micron as per the client’s requirements and also accept customization in various parameters.Yttrium Aluminate (Y3Al5O12) Nanopowder/Nanoparticles
$0.00
Yttrium Aluminate (Y3Al5O12) Nanopowder/Nanoparticles
Product Name:Yttrium Aluminate (Y3Al5O12) Nanopowder/Nanoparticles, Purity: 99.7+%, Size: 80 nm
Purity: 99.7+ %, Size: 80 nm
Technical Properties:
| Product Number | NCZ-RE-132-19 |
| PURITY | 99.7+ % |
| AVERAGE PARTICLE SIZE | 80 nm |
| COLOR | White |
| Molecular Weight | 163.89 |
| FORM | Powder |
| ELEMENTAL ANALYSIS (%) | |
| La | 0.006 |
| Sm | 0.002 |
| Eu | 0.007 |
| Gd | 0.003 |
| Ce | 0.003 |
| Fe | 2 µg/g |
| Cu | 3 µg/g |
| Ni | 2 µg/g |
| Si | 8 µg/g |
| Zn | 3 µg/g |
Note: We can manufacture and supply different particle sizes (Nano size range, Micron, Submicron, and different Mesh size) products of Alloy powders (Multi-Element, Multi-Element Oxide and Mixture of Rare Earth Elements) according to client’s requirements. Kindly ask for the customization in size and Element ratio composition.

Reviews
There are no reviews yet.